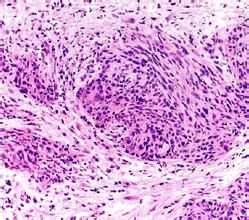
癌巢

癌巢無淋巴細胞浸潤。間質多數為纖維組織型,常伴有中性白細胞、淋巴細胞及漿細胞浸潤。EMA和CK(尤其是高分子量CK)呈強陽性反應。中等分化鱗狀細胞癌,癌組織中可見一定數量的細胞間橋或/和角化,但數量遠較高分化者為少。癌巢內有不等量淋巴細胞浸潤,巢周有數量不等的漿細胞。其間質特點同低分化鱗狀細胞癌。有時多數癌細胞核呈小、中等梭形,胞漿略嗜酸性或嗜雙色性,癌細胞呈束狀或編織狀排列(鱗狀細胞癌,梭形細胞亞型);有時多數癌細胞呈多邊形,細胞境界清楚,胞漿透明,核較小(鱗狀細胞癌,透明細胞亞型)。中等分化鱗狀細胞癌中,常可見癌細胞核增大,空泡狀,呈狀核細胞變。EMA和CK常呈陽性反應。低分化鱗狀細胞癌,癌組織中可見清楚的細胞間橋或/和角化,但數量極少。
相關詞條
-
浸潤性導管癌
浸潤性導管癌,非特殊性(導管NOS)是浸潤性乳腺癌分類中最大的一組異型腫瘤,由於缺乏豐富的特徵表現,難以象小葉癌或小管癌那樣將其分成一種特殊組織學類型。...
歷史名稱及意義 流行病學 肉眼檢查 組織病理學 伴有破骨細胞樣巨細胞的癌 -
闌尾炎癌
闌尾類癌(carcinoid of appendix)是胃腸道類癌中最常見的一種,主要位於闌尾的黏膜下層,70%~90%的闌尾類癌小於1cm。臨床多無明...
流行病學 發病機制 臨床表現 診斷 檢查 -
外陰轉移性癌
外陰轉移性癌(metastatic carcinoma of vulva)。外陰轉移性癌比較少見,全身其他部位的任何癌腫均有可能轉移至外陰,癌轉移至外陰...
流行病學 病因 臨床表現 診斷 鑑別診斷 -
胃類癌瘤
胃類癌瘤(英文名:carcinoid of stomach )是起源於胃黏膜嗜鉻細胞(APUD細胞)的惡性腫瘤,屬於神經內分泌腫瘤,胃類癌與其他胃惡性腫...
病因 類型 臨床表現 併發症 鑑別診斷 -
肝臟類癌
肝臟類癌(hepatic carcinoid)是指原發於肝臟的類癌,是一種極為罕見的生長緩慢的上皮細胞腫瘤具有惡變傾向臨床上僅有少數病人有類癌綜合徵(c...
流行病學 發病機制 病因和病理 臨床表現 診斷 -
眼瞼基底細胞癌
眼瞼基底細胞癌約占眼瞼惡性上皮性腫瘤的85%~95%95%以上病變發生於中老年人,平均年齡為60歲,無性別差異。眼瞼基底細胞癌可沿結膜侵犯淚道,並向眼眶...
流行病學 病因 發病機制 臨床表現 診斷 -
膀胱小細胞癌
膀胱小細胞癌(Smallcellcarcinomaoftheurinarybladder,SCBC),是泌尿系腫瘤中一種比較罕見的惡性腫瘤。但因其在臨...
疾病起源 臨床特點 診斷方法 生物免疫治療 治療預後 -
脈絡膜轉移癌
脈絡膜轉移癌,英文名:metastatic tumor of the choroid,脈絡膜血管豐富,血流緩慢,眼內又無淋巴管道,全身性腫瘤可經血運轉移...
流行病學 病因 臨床表現 診斷 治療及預後